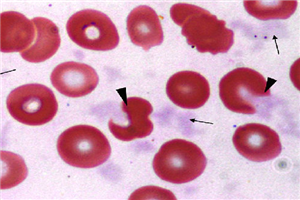

靶向药百科
*以上解读内容仅供参考,癌症123不对解读内容负责。
医生使用奥沙利铂(乐沙定)关注的要点
2018-04-13奥沙利铂(乐沙定)获批用来治疗转移性的结直肠癌,应在具有抗癌化疗经验的医师的监督下使用。为什么要在由有经验的医生下使用呢,主要是关于奥沙利铂(乐沙定)使用不当会出
奥沙利铂(乐沙定)在化疗过程中的注意事项有哪些?
2018-04-13奥沙利铂(乐沙定)作为第三地广谱化疗药品,在治疗癌症的过程中,经常会使用到,为了避免不必要的副作用,在在化疗过程中,奥沙利铂(乐沙定)注意事项有哪些?
(1) 禁止饮用
奥沙利铂(乐沙定)化疗过程中掉头发吗?
2018-04-13奥沙利铂(乐沙定)是第三代化疗药品,第一代是顺铂,第二代是卡铂。相比前两代奥沙利铂(乐沙定)有了很大的优势,那奥沙利铂(乐沙定)化疗过程中掉头发吗?
作为化疗药品
印度瑞宁得获得了广大乳腺癌患者的青睐!
2018-04-13说到瑞宁得,我们首先知道瑞宁得的适应症是绝经后妇女的晚期乳腺癌的治疗。适用于绝经后妇女雌激素受体阳性的早期乳腺癌的辅助治疗。而且副作用和不良反应非常小,乳腺癌
747元的瑞宁得哪里有?
2018-04-13瑞宁得作为乳腺癌的神药已经在中国成功上市了,而且疗效大家也是有目共睹的,因此吸引了很多人的纷纷购买浪潮,我们都知道国内的都是由英国阿斯利康生产的进口瑞宁得,价格高
全面评价赫赛汀治疗乳腺癌疗效
2018-04-13赫赛汀适用于HER2 过度表达的转移性乳腺癌,而且一上市就赢得了广大患者的欢迎,作为分子靶向药一直造福广大乳腺癌患者,而且确实延长患者的无进展生存期。
但是要从
乐伐替尼E7080延长肝癌50%的生存期
2018-04-13乐伐替尼E7080三期实验中的公布震惊了中国的肝癌圈,相比索拉菲尼,乐伐替尼在中国患者身上效果更加明显。
由于我国肝癌患者中有乙肝病毒感染的人较多,所以对有乙肝
乐伐替尼Lenvatinib包含在零关税进口药里面吗?
2018-04-13乐伐替尼Lenvatinib在三期实验里面的出色表现,使得肝癌患者欣喜不已,中国的患者更加向往使用乐伐替尼Lenvatinib治疗,那乐伐替尼Lenvatinib包含在零关税进口药里面吗?
乐伐替尼有多厉害,看着这些你就知道了!!!
2018-04-13乐伐替尼英文名字是Lenvatinib,商品名:Lenvima,是由日本卫材公司研发的抗癌药,2015年2月13日首获FDA批准用于分化型甲状腺癌,2016年5月13日再获批联合Everolimus用于肾细胞
抗癌神药赫赛汀能用于转移性胃癌吗?
2018-04-13赫赛汀作为一款非常热门的靶向药,随着医学研究的不断扩展,适应症也有更适应了很多的领域,而且随着生活水平的提高,中国胃癌的发生率也得到了很大的发展,那么赫赛汀能用于转
赫赛汀医保——让乳腺癌患者有了新希望
2018-04-13对于乳腺癌患者来讲,在2017年赫赛汀的成功医保确实给了患者非常大的盼头,意味着不用再被高价格所垄断,而且让普通老百姓也有了新的盼头。
据市场了解,靶向药赫赛汀是
赫赛汀的疗效为啥如此惊人!
2018-04-13由罗氏生产的一款最新乳腺癌新药,赫赛汀在一出世就赢得了世界的关注,主要是针对HER2 过度表达的转移性乳腺癌,而且众多的实验证实赫赛汀在安全性和有效性方面都得到了证实
5750元的印度赫赛汀疗效如何?
2018-04-13都知道赫赛汀是由罗氏生产的一款乳腺癌新药,对HER2 过度表达的转移性乳腺癌非常有效,而且降低了疾病恶化风险,经过这么长时间的临床结果来看在安全性和有效性方面非常的显
印度来多吉美治疗肝癌的良心药
2018-04-13根据【2017年中国癌症报告】数据了解到每天约有一万人确证癌症,平均每分钟就有7人确诊。中国是癌症大国,癌症患者大约占据着全球40%。目前治疗癌症最普遍的方法就是手术
国内氟维司群医院售价多少钱?
2018-04-13氟维司群近几年来最为内分泌的新药兴起,给了我们非常大的福利,显著提高了患者的生存质量,面对乳腺癌的一直肆虐,氟维司群也成功拯救了很多在生死边缘挣扎的患者。
而
帕尼单抗在美国和欧盟分辨用来治疗什么疾病?
2018-04-13欧盟和美国的医疗水准都是比较高的,在治疗癌症方面,很多的药品都是优先上市获批,那帕尼单抗在美国和欧盟分辨用来治疗什么疾病?
在欧盟,帕尼单抗Vectibix的适应症为W
2018年帕尼单抗Panitumumab的价格是多少?
2018-04-13帕尼单抗Panitumumab是目前为止第一个完全人源化单克隆抗体,主要是用来治疗结直肠癌,那2018年帕尼单抗Panitumumab的价格是多少?
目前这个药品在国内还没有上市,所
帕尼单抗VS西妥昔单抗(爱必妥),谁输谁赢?
2018-04-13在转移性结直肠癌的患者中,很多的人都是EGFR靶点的,这个时候治疗的药品比较多,比较权威的治疗方案是帕尼单抗和西妥昔单抗(爱必妥),在使用这两种药品的过程中,那个效果更好,
老年患者能用帕尼单抗Panitumumab吗?
2018-04-13目前国内老年化进一步加剧,而在患者中,老年人占了很大一部分,那老年患者能用帕尼单抗Panitumumab吗?
在研究1中229例接受帕尼单抗Panitumumab的患者中,其中96例(42%)
氟维司群医保后患者看到了希望吗?
2018-04-13作为乳腺癌内分泌最受宠的药物氟维司群,成功的俘获了患者的心声,而且非常利好的一个消息就是氟维司群已经成功入医保了,给了我们很大的希望,由于我国女性乳腺癌一直处于直
靶向神药氟维司群服药期间留意哪些!
2018-04-13提到乳腺癌的神药氟维司群非常受到瞩目,而且疗效也是非常好,氟维司群是一款非常受欢迎的乳腺癌内分泌药物,在乳腺癌患者的治疗之中内分泌治疗是非常受欢迎的,在2015年一上
选择多吉美的利与弊?
2018-04-13俗话说的好,是药总有三分毒。多吉美作为目前治疗肝癌的一线靶向药。其效果也是被世界所公认的。但事物总是有两面性,有好处也有坏处。
多吉美作为治疗不能手术的晚期
服用卡巴他赛(Cabazitaxel)出现腹泻如何应对?
2018-04-13卡巴他赛通过抑制细胞分裂和生长来杀死癌细胞。卡巴他赛通过抑制微管生长和装配来发挥其作用,这是细胞分裂所必需的过程。
有医生为您推荐服用缓解腹泻的药物。此外,尝
依维莫司成功入医保,乳腺癌带来新希望!
2018-04-13作为非常热门的乳腺癌药物依维莫司给了我们更多的期盼,而且在2017年依维莫司成功被列入医保,因此给了患者更多的期望,飞尼妥作为靶向药物确实显著抑制肿瘤的生殖和扩散。
浅谈泊马度胺治疗多发性骨髓瘤
2018-04-13泊马度胺于2013年2月8日被美国食品药品监督管理局(FDA)批准用于至少经过两种治疗无效(包括来那度胺和硼替佐米)和最后一次治疗后60天内病情恶化的患者。
泊马度胺是